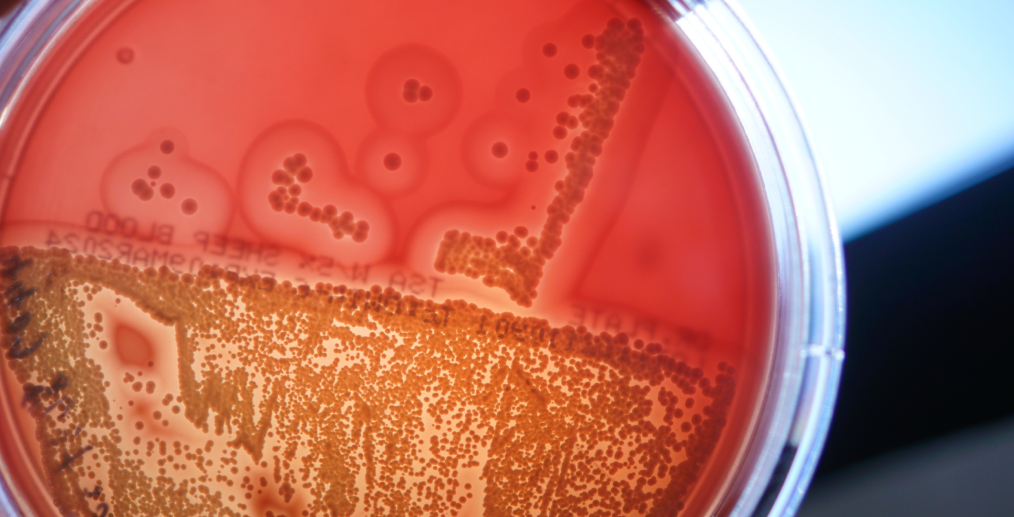
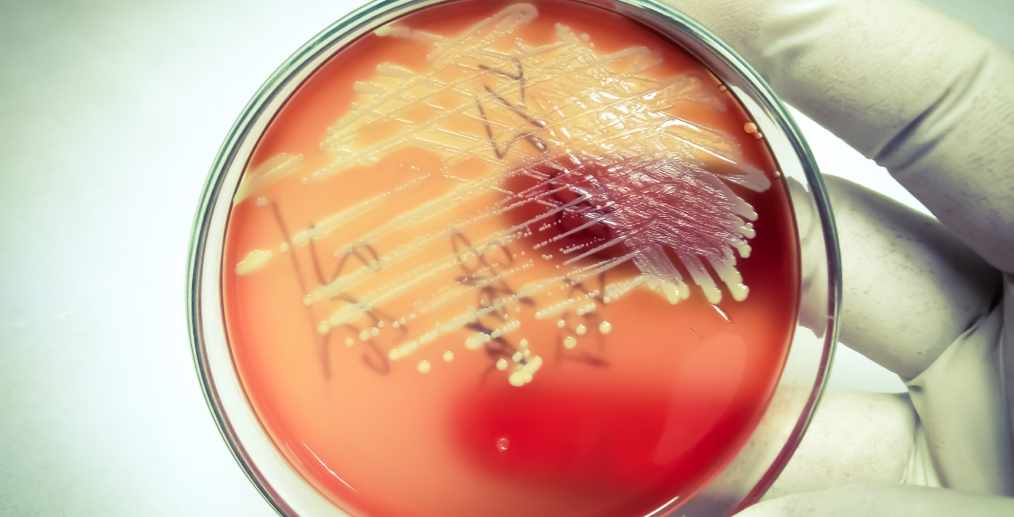

Ce trebuie să știi pe scurt
- Ce este? Sindromul pielii opărite stafilococice (SPOS) este o infecție bacteriană severă, dar rară, a pielii, cauzată de toxinele eliberate de o tulpină de Staphylococcus aureus. Se manifestă prin roșeață, vezicule și descuamarea pielii în foițe, dând aspectul unei arsuri sau opăriri.
- Cine este afectat? Cel mai frecvent apare la nou-născuți și copiii mici sub 5 ani, din cauza imunității incomplet dezvoltate și a rinichilor care nu elimină toxinele la fel de eficient ca la adulți.
- Este urgent? Da, SPOS este o urgență medicală. Necesită spitalizare imediată pentru tratament cu antibiotice intravenoase și îngrijirea leziunilor pielii pentru a preveni deshidratarea și infecțiile secundare grave.
- Cum se diagnostichează? Diagnosticul clinic este confirmat rapid prin analize de laborator esențiale, precum hemoleucograma și markerii inflamatori (CRP, VSH), dar mai ales prin hemocultură și culturi din zonele infectate, pentru a identifica bacteria și sensibilitatea ei la antibiotice.
Te invităm să citești articolul complet pentru a înțelege cum să recunoști simptomele timpurii ale acestei afecțiuni și de ce rapiditatea diagnosticului de laborator poate salva vieți.
Ce este sindromul pielii opărite stafilococice (SPOS)?
Sindromul pielii opărite stafilococice, cunoscut și sub numele de boala Ritter (la nou-născuți), este o boală infecțioasă gravă a pielii, declanșată de anumite toxine produse de bacteria Staphylococcus aureus.
Cine este afectat în mod obișnuit?
Deși poate apărea la orice vârstă, SPOS este mult mai frecvent la:
- Nou-născuți și sugari: sistemul lor imunitar este încă în dezvoltare și nu are suficienți anticorpi specifici pentru a neutraliza toxinele stafilococice.
- Copiii sub 5 ani: rinichii lor sunt încă imaturi și nu pot elimina toxinele din sânge la fel de eficient ca rinichii unui adult.
- Adulții imunocompromiși sau cei cu insuficiență renală cronică.
Cauzele și mecanismul bolii: cum provoacă stafilococul sindromul pielii opărite?
Cauza directă a SPOS este infecția cu o tulpină specifică de Staphylococcus aureus (stafilococ auriu) care produce două toxine exfoliative (ETA și ETB). Aceste toxine sunt eliberate de bacterie într-un focar de infecție, care poate fi aparent minor, cum ar fi o infecție la nivelul cordonului ombilical, o conjunctivită, o infecție ORL sau o simplă zgârietură infectată.
Mecanismul acțiunii toxinelor:
- Bacteriile se multiplică într-un focar localizat (de exemplu, nas sau gât) și eliberează toxinele.
- Toxinele intră în fluxul sanguin și se răspândesc în tot corpul.
- Ajunse la nivelul pielii, toxinele atacă și distrug o proteină specifică (desmogleina 1), responsabilă de menținerea aderenței dintre celulele stratului superficial al epidermului.
- Distrugerea acestei proteine duce la desprinderea stratului superior al pielii, formând vezicule și zone denudate, lăsând organismul vulnerabil la pierderi de lichide și alte infecții.
Este important de reținut că, în cazul SPOS, leziunile extinse de pe piele (bășicile și zonele descuamate) nu conțin bacterii, fiind sterile. Bacteriile sunt prezente doar în focarul inițial al infecției.
Cum recunoști semnele de alarmă? Etapele de evoluție la copii

Simptomele SPOS apar brusc și evoluează rapid. Recunoașterea lor precoce este esențială pentru instituirea tratamentului de urgență. Evoluția tipică presupune următoarele etape:
1. Faza inițială (prodromală)
Copilul devine agitat, plânge mult și are o stare generală proastă. Apare febra (adesea ridicată), uneori însoțită de frisoane. Pielea devine extrem de sensibilă și dureroasă la atingere, chiar și la cea mai blândă mângâiere.
2. Faza de erupție cutanată
Apar pete roșii, difuze, care se extind rapid, începând adesea din jurul gurii, nasului, ochilor sau din zona scutecului, cuprinzând apoi trunchiul și membrele. Pielea capătă un aspect roșu intens, ca de arsură solară, și este foarte caldă la atingere.
3. Faza de descuamare (exfoliere)
În decurs de 24-48 de ore de la apariția roșeții, se formează vezicule mari, pline cu lichid clar. Aceste vezicule sunt foarte fragile și se sparg ușor la cea mai mică presiune sau frecare (semnul Nikolsky pozitiv), lăsând în urmă zone roșii, umede și strălucitoare, care par opărite. Desprinderea pielii se face în lambouri mari, asemănătoare unor foițe de țigară.
De ce este urgentă intervenția medicală în SPOS?
Sindromul pielii opărite stafilococice este o urgență medicală care necesită spitalizare imediată, adesea în secția de terapie intensivă sau într-o unitate specializată de arsuri. Gravitatea bolii provine din faptul că pielea, organul nostru protector, este compromisă pe suprafețe mari.
Riscurile majore care impun tratament de urgență sunt:
- Deshidratare severă și dezechilibru electrolitic: pierderea stratului protector al pielii duce la evaporarea masivă a apei și pierderea de săruri minerale esențiale, similar cu o arsură gravă. La bebeluși, acest lucru poate duce rapid la șoc hipovolemic.
- Infecții secundare (suprainfecții): zonele de piele denudată sunt porți deschise pentru alte bacterii (inclusiv Pseudomonas sau alți stafilococi), care pot provoca infecții locale grave sau sepsis (infecție generalizată în sânge), punând viața în pericol.
- Hipotermie: pierderea capacității pielii de a regla temperatura corpului.
Ce analize de laborator sunt esențiale pentru a confirma diagnosticul?
Diagnosticul SPOS se bazează în primul rând pe aspectul clinic caracteristic al pielii și pe evoluția rapidă a simptomelor. Totuși, analizele de laborator sunt esențiale pentru a confirma diagnosticul, a evalua starea generală a copilului și, cel mai important, pentru a identifica bacteria responsabilă și tratamentul corect.
Rolul hemoleucogramei și al markerilor inflamatori
Testele de sânge de bază oferă o imagine rapidă a răspunsului organismului la infecție și a gradului de afectare.
Hemoleucograma completă
Este primul pas în evaluarea oricărei infecții severe. La un copil cu SPOS, aceasta va arăta de obicei un număr crescut de leucocite (globule albe), în special neutrofile, semn al unei infecții bacteriene active.
? Poliana, rețeaua de laboratoare și policlinici dedicată sănătății tale, efectuează hemoleucograma cu formulă leucocitară în regim de urgență, oferind rezultate rapide medicilor curanți.
Rolul proteinei C reactive (CRP) în evaluarea inflamației
Proteina C reactivă (CRP) este o proteină produsă de ficat al cărei nivel în sânge crește rapid ca răspuns la inflamația acută din organism. În cazul SPOS, care este o infecție bacteriană severă ce declanșează o reacție inflamatorie sistemică puternică, valorile CRP vor fi, de obicei, semnificativ crescute.
Dozarea cantitativă a CRP este un instrument valoros nu doar pentru confirmarea prezenței unei inflamații acute, ci și pentru monitorizarea eficienței tratamentului. O scădere a nivelului de CRP în zilele următoare inițierii antibioticelor indică un răspuns favorabil la terapie.
? Poliana oferă analiza de proteina C reactivă (CRP) cantitativ, esențială pentru evaluarea rapidă a gradului de inflamație.
Viteza de sedimentare a hematiilor (VSH) ca indicator de fază acută
Viteza de sedimentare a hematiilor (VSH) este un alt test de sânge nespecific, dar foarte utilizat, care măsoară cât de repede se depun globulele roșii (hematiile) la baza unei eprubete într-o oră. Prezența proteinelor inflamatorii în sânge (cum sunt cele produse în timpul unei infecții precum SPOS) face ca hematiile să se lipească între ele și să sedimenteze mai rapid, ducând la o valoare VSH crescută.
? Deși CRP-ul reacționează mai rapid la inflamația acută, VSH-ul rămâne un marker util, adesea folosit în combinație cu CRP-ul pentru a obține o imagine mai completă a procesului inflamator și a evoluției acestuia în timp. Poți afla mai multe despre această analiză și importanța ei în ghidul Poliana despre VSH – Viteza de sedimentare a hematiilor.
Hemocultura și culturile din leziuni: identificarea bacteriei
Cel mai important pas în diagnosticul de laborator al SPOS este identificarea exactă a bacteriei Staphylococcus aureus care produce toxinele. Deoarece leziunile de pe piele (bășicile) sunt sterile, probele nu se recoltează de acolo.
- Culturile din focarul primar: Se recoltează probe (secreții) din zonele suspectate a fi sursa inițială a infecției: nas, gât, ochi, bontul ombilical la nou-născuți sau orice altă rană vizibilă.
- Hemocultura: Deși bacteria nu este întotdeauna prezentă în sânge (deoarece simptomele sunt cauzate de toxinele circulante, nu de bacterie în sine), hemocultura este obligatorie la orice copil febril și suspect de o infecție severă. Dacă este pozitivă, aceasta confirmă bacteriemia și permite identificarea bacteriei.
? Odată izolată bacteria, se efectuează antibiograma pentru a determina la ce antibiotice este sensibilă tulpina respectivă. Poliana oferă antibiograma pentru Staphylococcus spp., un test esențial care ghidează medicul în alegerea antibioticului cel mai eficient, salvând timp prețios și crescând șansele de vindecare rapidă.
Poliana: precizie de laborator și rezultate prompte în situații de urgență
În fața unei urgențe medicale precum sindromul pielii opărite stafilococice, timpul este un factor critic. Rapiditatea cu care se obțin rezultatele analizelor de laborator poate influența decisiv deciziile terapeutice ale medicilor pediatri și, implicit, prognosticul micului pacient.
Poliana înțelege această nevoie acută de promptitudine și acuratețe. Rețeaua noastră de laboratoare este dotată cu tehnologie de ultimă generație și dispune de personal specializat, pregătit să proceseze analizele în regim de urgență. De la hemoleucograma completă și markerii inflamatori (CRP, VSH), până la hemoculturi și antibiograme complexe, ne angajăm să oferim rezultate precise în cel mai scurt timp posibil, sprijinind eforturile echipelor medicale în lupta contra infecțiilor severe.
De ce este important un diagnostic diferențial? Distincția de alte afecțiuni
Simptomele SPOS pot fi confundate cu alte afecțiuni dermatologice grave, iar tratamentul greșit poate fi periculos. Medicul specialist trebuie să facă distincția între SPOS și alte boli similare.
Tabel cu principalele afecțiuni de care trebuie diferențiat SPOS
| Afecțiunea similară | Caracteristici distinctive față de SPOS |
| Necroliza epidermică toxică (Lyell)
Sindromul Stevens-Johnson |
Sunt reacții severe la medicamente, nu infecții bacteriene. Afectează frecvent și mucoasele (gură, ochi, zona genitală), ceea ce este rar în SPOS. |
| Arsuri termice sau chimice | Există un istoric clar al unui accident cu un agent termic (lichid fierbinte, foc) sau chimic. |
| Impetigo bulos | Este tot o infecție stafilococică, dar rămâne localizată. Veziculele conțin bacterii (în SPOS sunt sterile), iar starea generală a copilului este de obicei bună, fără febră mare. |
? SPOS nu trebuie confundat cu alte infecții cutanate stafilococice, cum ar fi boala impetigo, care este mult mai frecventă, mai puțin severă și rămâne, de obicei, localizată la nivelul pielii, fără a se extinde sistemic prin intermediul toxinelor.
Cum se tratează sindromul pielii opărite la nou-născuți și copiii mici?
Tratamentul se desfășoară exclusiv în spital și are două componente majore:
Tratamentul cauzei (antibioterapia)
Se administrează antibiotice intravenoase puternice (de exemplu, oxacilină, clindamicină sau vancomicină, în funcție de rezistența bacteriei) pentru a distruge stafilococul din focarul infecțios și a opri producția de toxine. Cu cât tratamentul începe mai repede, cu atât prognosticul este mai bun.
Tratamentul de susținere și îngrijirea pielii
Este vital și similar cu cel al pacienților cu arsuri.
- Rehidratare intravenoasă: pentru a compensa pierderile masive de lichide și a menține funcția renală.
- Îngrijirea leziunilor: pielea se curăță cu soluții antiseptice blânde, iar zonele denudate se acoperă cu pansamente speciale, neaderente, pentru a preveni infecțiile secundare și a reduce durerea.
- Controlul durerii: se administrează analgezice adecvate vârstei.
Dacă este diagnosticat și tratat prompt, majoritatea copiilor cu SPOS se vindecă în 10-14 zile, iar pielea se regenerează fără cicatrici pe termen lung, deoarece stratul profund al pielii (dermul) nu este afectat.
Cum pot fi prevenite infecțiile cu stafilococ? Recomandări pentru îngrijirea pielii

Deoarece stafilococul auriu este o bacterie comună, prezentă frecvent pe pielea și în nasul multor persoane sănătoase, prevenția totală este dificilă. Totuși, riscul de infecții severe poate fi redus prin măsuri simple de igienă:
- Spălarea frecventă a mâinilor: cea mai eficientă metodă de a preveni răspândirea bacteriilor, în special înainte de a atinge bebelușul sau de a-i schimba scutecul.
- Îngrijirea corectă a bontului ombilical la nou-născuți.
- Curățarea și dezinfectarea promptă a oricărei răni, tăieturi sau zgârieturi.
- Evitarea contactului cu persoane care au infecții active ale pielii (impetigo, furuncule).
Cu o rețea extinsă de laboratoare, puncte de recoltare și policlinici la nivel național, Poliana aduce serviciile medicale de calitate mai aproape de oameni. Portofoliul său acoperă o gamă completă de analize de laborator. Echipa Poliana se ghidează după valori precum integritatea și competența, iar procedurile utilizate respectă standardele de calitate atestate prin certificări specifice domeniului medical.
⚠️ Disclaimer: Acest articol este cu titlu informativ și nu constituie o recomandare medicală. Informațiile din acest material nu înlocuiesc consultul medical sau recomandările specialistului.
Surse:
- National Center for Biotechnology Information (NCBI), Staphylococcal Scalded Skin Syndrome, 2025, https://www.ncbi.nlm.nih.gov/books/NBK448135/
- Johns Hopkins Medicine, Staphylococcal Scalded Skin Syndrome, https://www.hopkinsmedicine.org/health/conditions-and-diseases/staphylococcal-scalded-skin-syndrome
- British Association of Dermatologists (BAD), Staphylococcal Scalded Skin Syndrome, 2023, https://www.bad.org.uk/pils/staphylococcal-scalded-skin-syndrome
- MSD Manual, Staphylococcal Scalded Skin Syndrome, 2023, https://www.msdmanuals.com/professional/dermatologic-disorders/bacterial-skin-infections/staphylococcal-scalded-skin-syndrome








